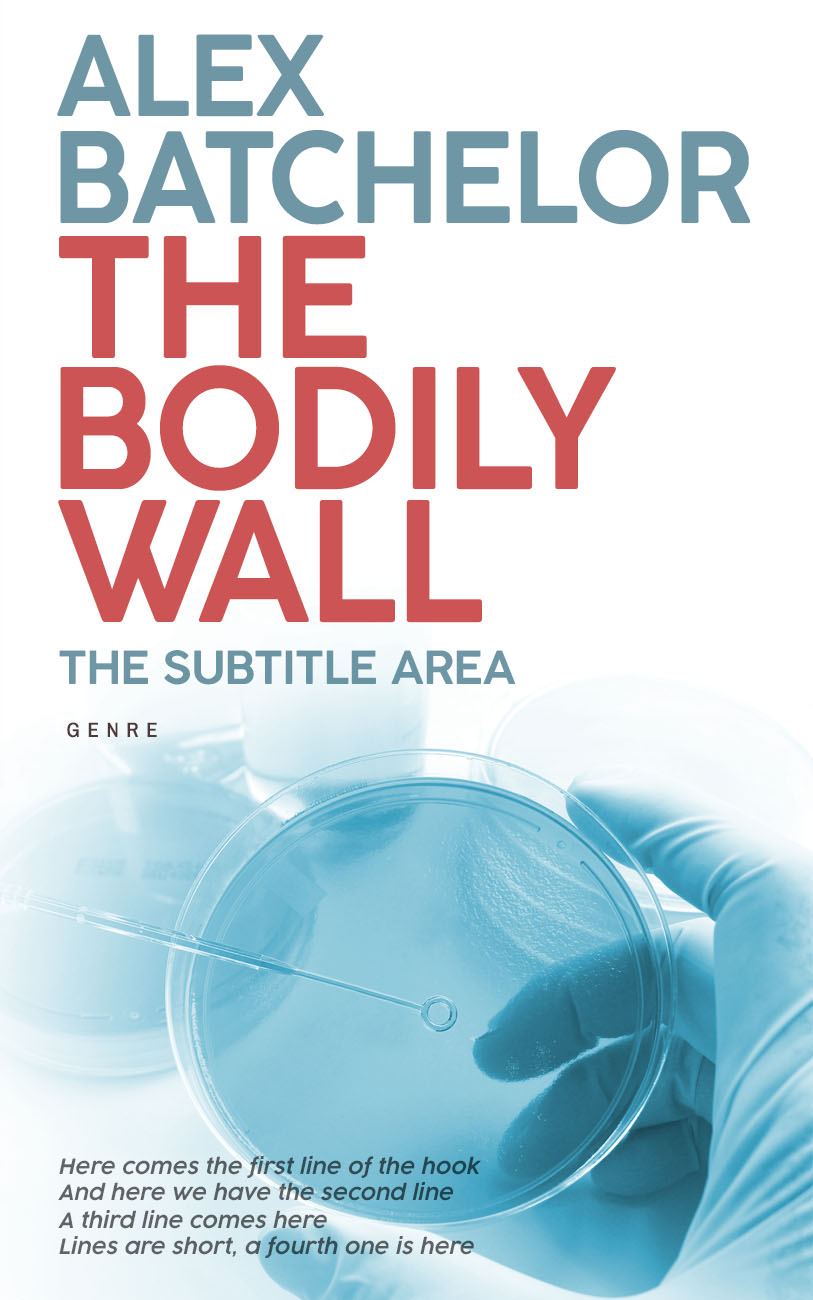

Purchase this book cover, starting from $99.00!
EBook Cover
$99.00
- Professional EBook Cover Design
- High Resolution Files
- Multiple Format Support
- Commercial Rights Included
EBook Cover + Print
$178.00
- Professional EBook Cover Design
- High Resolution Files
- Multiple Format Support
- Commercial Rights Included
- Print-Ready Cover Design
EBook Cover + Print + Title Page + Social Media Banners + Mockups
$226.00
- Professional EBook Cover Design
- High Resolution Files
- Multiple Format Support
- Commercial Rights Included
- Print-Ready Cover Design
- Custom Title Page
- Social Media Banner Set
- Marketing Mockups
EBook Cover + Title Page + Social Media Banners + Mockups
$147.00
- Professional EBook Cover Design
- High Resolution Files
- Multiple Format Support
- Commercial Rights Included
- Custom Title Page
- Social Media Banner Set
- Marketing Mockups

Reach out to the book cover designer of this cover!
Work with the worlds finest book cover designers to get a premium book cover for the fraction of the price of traditional designers, thanks to our innovative new approach. Even though this is a premade cover, you might need a few revisions to get the ideal cover for your book. You can now reach the book cover designer directly by writing to support@bookcoverzone.com. For a full list of our additional customization services feel free to take a look at our Customization Services. You will be able to work directly with the designer of the cover that you have purchased.
Market your book like a professional publishing house with unique social media marketing materials!
Once you've prepared your book and put it on sale in various market places, you will need a comprehensive marketing strategy and most of it will be oriented around social media services. BookCoverZone offers professional marketing materials for Facebook, Twitter, Instagram and LinkedIn for only $29! Just click on SOCIAL MEDIA MARKETING MATERIALS on the top of this page once you have prepared your cover and see your social media marketing materials immediately or purchase it directly by clicking on this button.
Transform your manuscript into a stunning e-book or printed book with BookBuilder! For free!
BookBuilder, a new service from BookCoverZone, automatically transforms your manuscript into a upload-ready ePub/MOBI file or print-ready PDF file. Your book will be fully compatible with Amazon's services (Kindle and KDP) so instead of going back and forth and paying hundreds of dollars to a designer you can now obtain the perfect book layout for free! And even better, instead of waiting for days for a designer to work on your manuscript, you will have your upload-ready files at hand in minutes!
Don't forget to get the full cover in case you plan on having your book published in printed format as well!
Amazon's self-publishing service Kindle Direct Publishing (KDP) is giving you the opportunity to publish your book for free in a printed format. We'll prepare your full paperback cover (front, spine and back) for an additional charge of $79 according to the Submission Guidelines set forth by Amazon. Included in the price we also offer a wide range of 3D mockups of your book.
Select Font
Roboto
The quick brown fox
Loading fonts...